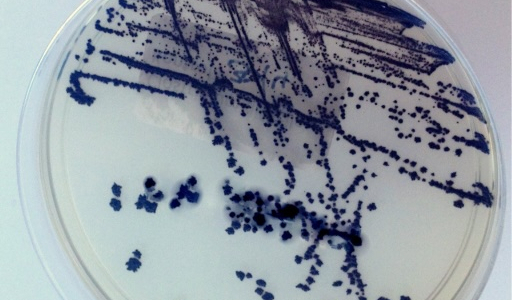
Infektionen durch Clostridioides difficile: Prävention und Rolle von Enterosorbenzien

Was ist Durchfall?
Durchfall macht sich durch häufigeres Entleeren von größerem Umfang ungeformten Stuhls bemerkbar. Wichtig ist besonders die ungeformte Konsistenz des Stuhlgangs, höhere Frequenz allein ist nicht immer Durchfall. Akuter Infektionsdurchfall kann von Schüttelfrost und Erbrechen begleitet werden.
Häufige Ursache von akutem Durchfall sind Vergiftungen durch Speisen oder Getränke (Toxine von Bakterien, die sich im Essen vermehrt haben, oder virulente und bakterielle Infektionen. Ursache können auch Diätfehler oder antibiotische Behandlung sein.